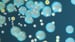
Tobramycin Tames Infection in Bronchiectasis

The presence of a positive fungal culture in patients with bronchiectasis does not appear to correlate with disease severity or any increased risk of an adverse outcome, according to data pulled from the Bronchiectasis and NTM Registry and presented at the 6th World Bronchiectasis & NTM Conference.
"The question we were asking is whether there is some signal that suggests we need to take care of these patients differently, and the answer is no," reported Pamela J. McShane, MD, a pulmonologist on the faculty at the University of Texas Health Science Center at Tyler.
When compared for outcome over time, those with a positive fungal culture at initial evaluation did not have more exacerbations, more hospitalizations, or other signs of a more severe disease or more complex course than those without a positive fungal culture.
When fungal infections are detected in an initial microbiologic evaluation of patients with bronchiectasis or other lung diseases, first-line clinicians generally assume that coverage is needed. McShane noted that many of the patients referred to her with bronchiectasis and a positive fungal culture were already on an antifungal.
These data are not supportive of treatment in the absence of fungal-related complications. McShane suggested they even raise questions about the value of culturing beyond bacterial pathogens in the absence of suspicion that fungal organisms are playing a role in symptoms. She cautioned, however, that more studies specifically studying this possibility are needed.
Study Details
The data were drawn in December 2022 from the US-based Bronchiectasis and NTM Registry, which at that time had 22 participating sites. Of the more than 5000 patients enrolled, the study looked at 2230 after several exclusions, such as a diagnosis of allergic bronchopulmonary aspergillosis (ABPA).
Of these 2230 patients, 949 had a fungal infection at the time of diagnosis and 1281 did not. Those with a fungal infection were further subdivided into those with an aspergillosis (331 patients) and those with a nonaspergillosis fungal infection (751 patients). The total of these two numbers is greater than the total number of fungal infections because these were not mutually exclusive.
At enrollment into the registry, there were no statistical differences between groups for age. Some statistical differences were observed among groups stratified by race, but McShane doubted that these were clinically significant with the exception of a potential disparity among Asians that might deserve further analysis.
Infection Results
Of clinical features evaluated for their association with fungal infection, there was no correlation with either body mass index or history of asthma. Eosinophilia was associated significantly with positive fungal cultures.
Interestingly, baseline FEV1 was slightly lower among those with a positive fungal culture even if the difference was highly significant (P = .0006). Again, McShane questioned the clinical significance of values that varied by only a few percentage points, even though she was willing to acknowledge that higher is always preferable to a lower FEV1.
In the context of other pathogens, "generally speaking, those with a positive bacterial culture were more likely to have a fungal infection," McShane reported, although there was some variation when looking at pathogenicity of the bacteria and other variables.
"Whether this [higher rate of fungal infection] just involves the environment or our antibiotics are driving the opportunity to permit the fungi to exist, we do not have the answer," she added.
Nontuberculosis mycobacteria (NTM) infection was similarly represented in those with or without a fungal infection, according to McShane. Noting the high use of antibiotics in an NTM population, McShane conceded that this challenges the theory that antibiotic use is driving the risk of fungal infection, but these are what the data say.
Steroid use was associated with a statistically significant risk of fungal infection, but McShane said it is unclear whether steroid use drives the risk or is an epiphenomenon.
"We looked at this a lot of different ways: oral vs inhaled and oral vs inhaled and oral, and it did not make much difference. Generally speaking, the fungal cultures were more likely to be positive in patients on any kind of steroid," she said.
Finally, with the exception of the slightly lower FEV1 in patients with fungal infections, McShane said that there was no discernible relationship between the presence of a fungal infection and severity of bronchiectasis.
Because of this evidence, McShane concluded that the presence of fungus in the culture of patients with bronchiectasis does not appear to correlate with outcome or severity. Since completing the study, she said she is now using these data to reassure patients who have a positive fungal culture.
While these data do not affect the need to diagnosis fungal infections in patients who are not responding typically to therapy or otherwise have an abnormal course of bronchiectasis, raising suspicion that fungal infection is participating in the disease course, the data provide a basis for questioning whether routine cultures are needed, according to the discussion that followed McShane’s presentation.
Expert Opinion
Several of the experts at the presentation provided an opinion. Some reported that they would continue to order fungal cultures on a routine basis, while others said that they now, on the basis of these data, plan to order cultures only at the first visit or when fungal infection is suspected of exacerbating the disease.
Of this latter group, which seemed to be dominant, Juzar Ali, MD, professor of Medicine, Louisiana State University School of Medicine, New Orleans, said that he has not been ordering fungal cultures on every visit. Rather, he has been doing so selectively. Examples include those who are on steroids or those with an unusual pattern of exacerbations.
"The value of these data is that they have now provided some data to support this approach," said Ali in an interview. Noting that this is the first large study to address this question in a systematic way, he considers this to be a valuable contribution for approaching a common clinical issue.
McShane reports no relevant financial relationships. Ali reports a financial relationship with Insmed.
World Bronchiectasis and NTM Conference: The presentation took place Wednesday, July 19, 2023.
For more news, follow Medscape on Facebook, Twitter, Instagram, and YouTube.
Credit:
Lead image: The Centers for Disease Control and Prevention
Medscape Medical News © 2023
Cite this: Fungal Cultures in Bronchiectasis Don’t Predict Outcomes - Medscape - Jul 20, 2023.

Comments